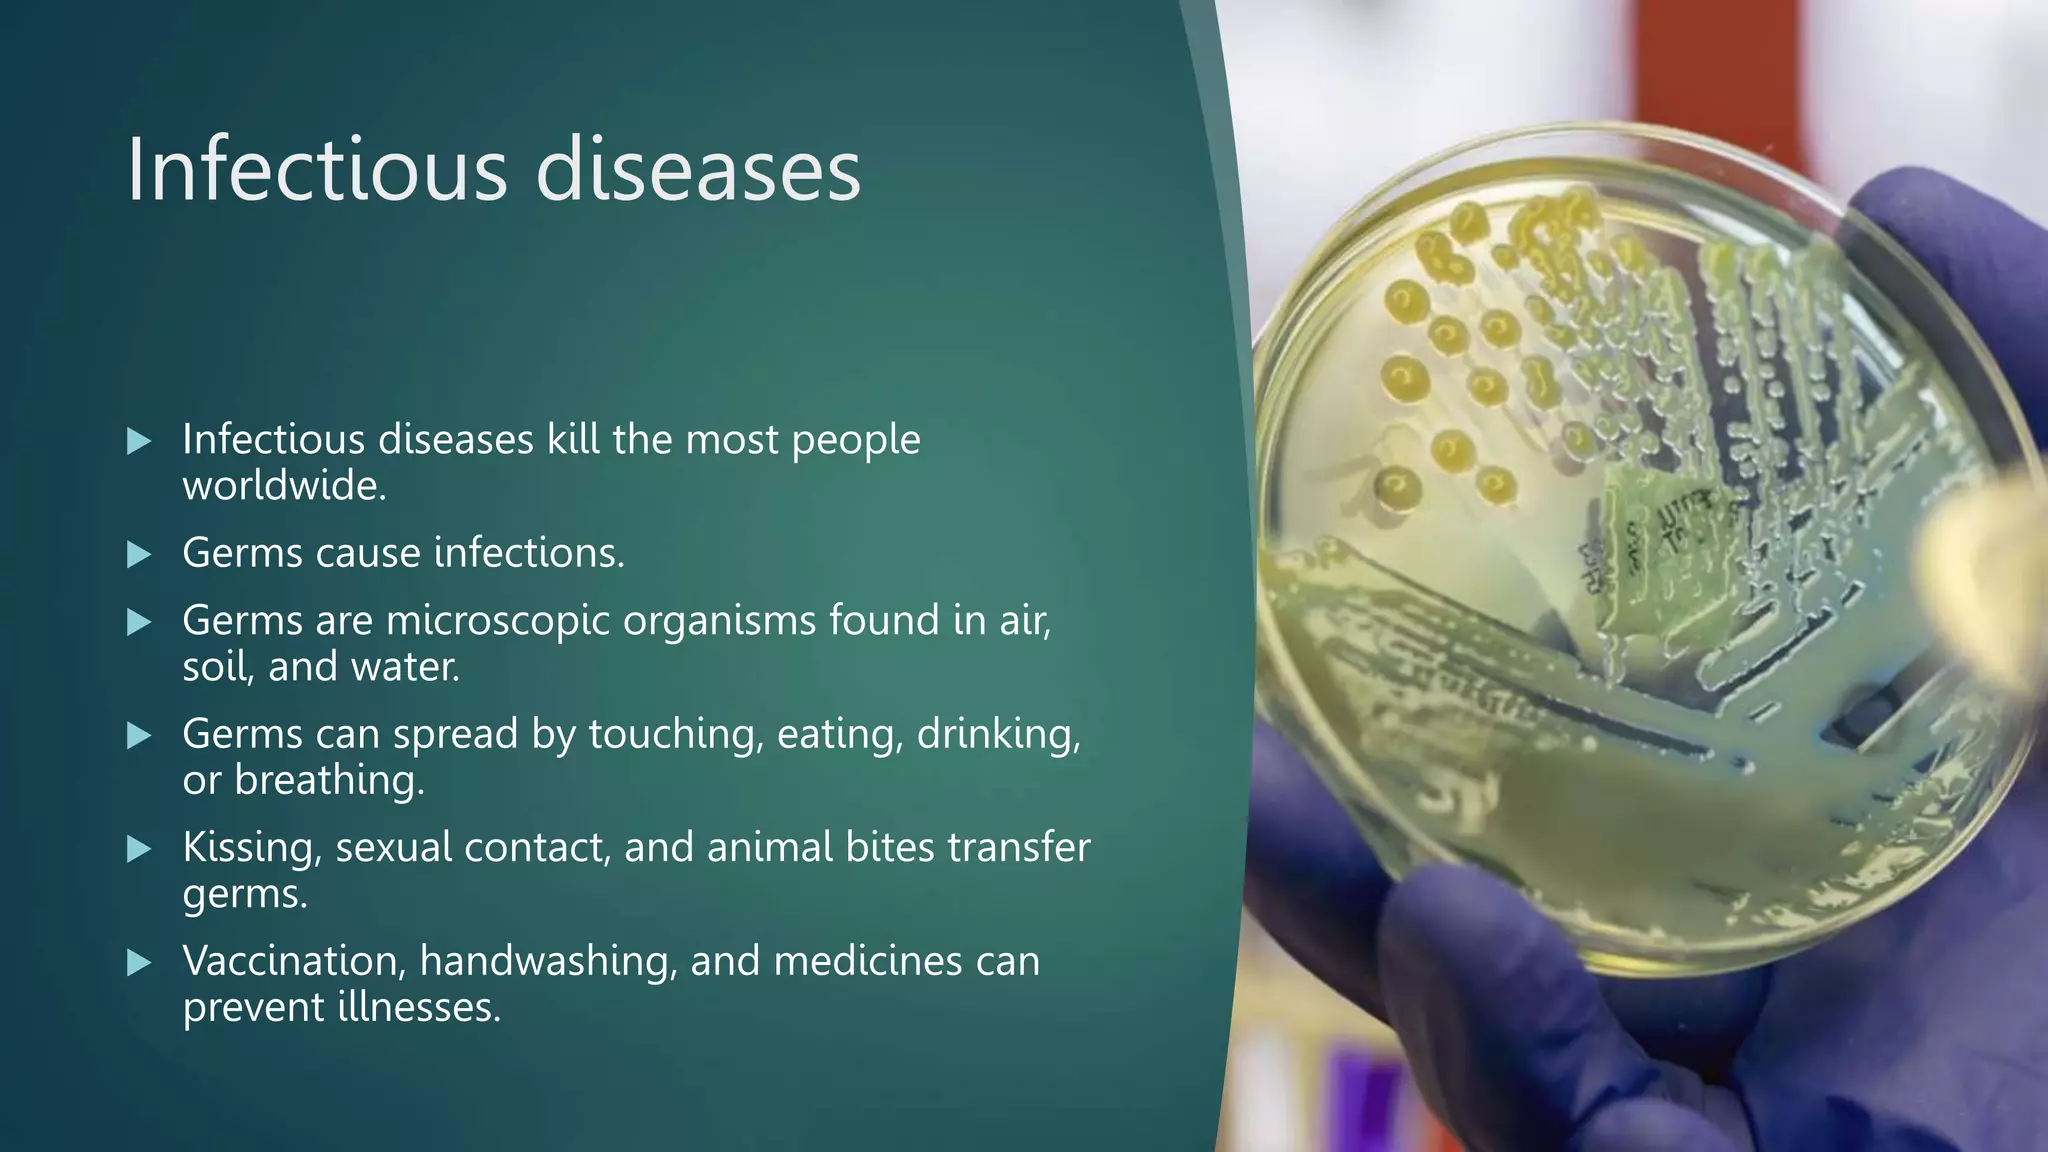
Infection Control Prevention PPTX

Infection Free Zone Best Starting Location
Infection Free Zone Best Starting Location - Here are some of the images for Infection Free Zone Best Starting Location that we found in our website feer.edu.pl database, related for Asl 3.2 Worksheet Part 1, Candy Gram Template, Picku App Download Apk, Free Swagbucks Codes Worth 1000, Nay Varan Bhat Loncha Kon Nay Koncha Watch Online Free, Ulta Coupon Code $15 Off $75 Printable, Free Car Coloring Sheets, Air Words Worksheet, Planet Ban Apk, Download Game Apk Offline,

Bacterial Infections ChemoExperts

Breaking The Chain Of Infection Quiz

MICROBIAL INFECTIONS OF HUMANS(HUMAN MICROBIOLOGY CONTD )

Infection Types And Causes Infoupdate org

Mapping SARS CoV 2 Infections in the Respiratory Tract Inside

Infectious Diseases Viral Fungal and Parasitic Disease Overview
Infection Control Prevention PPTX

Symptoms

Infection Cycle Bacterial Infection Cause And Further Treatment

Is Your Infection Bacterial or Viral? University Hospitals